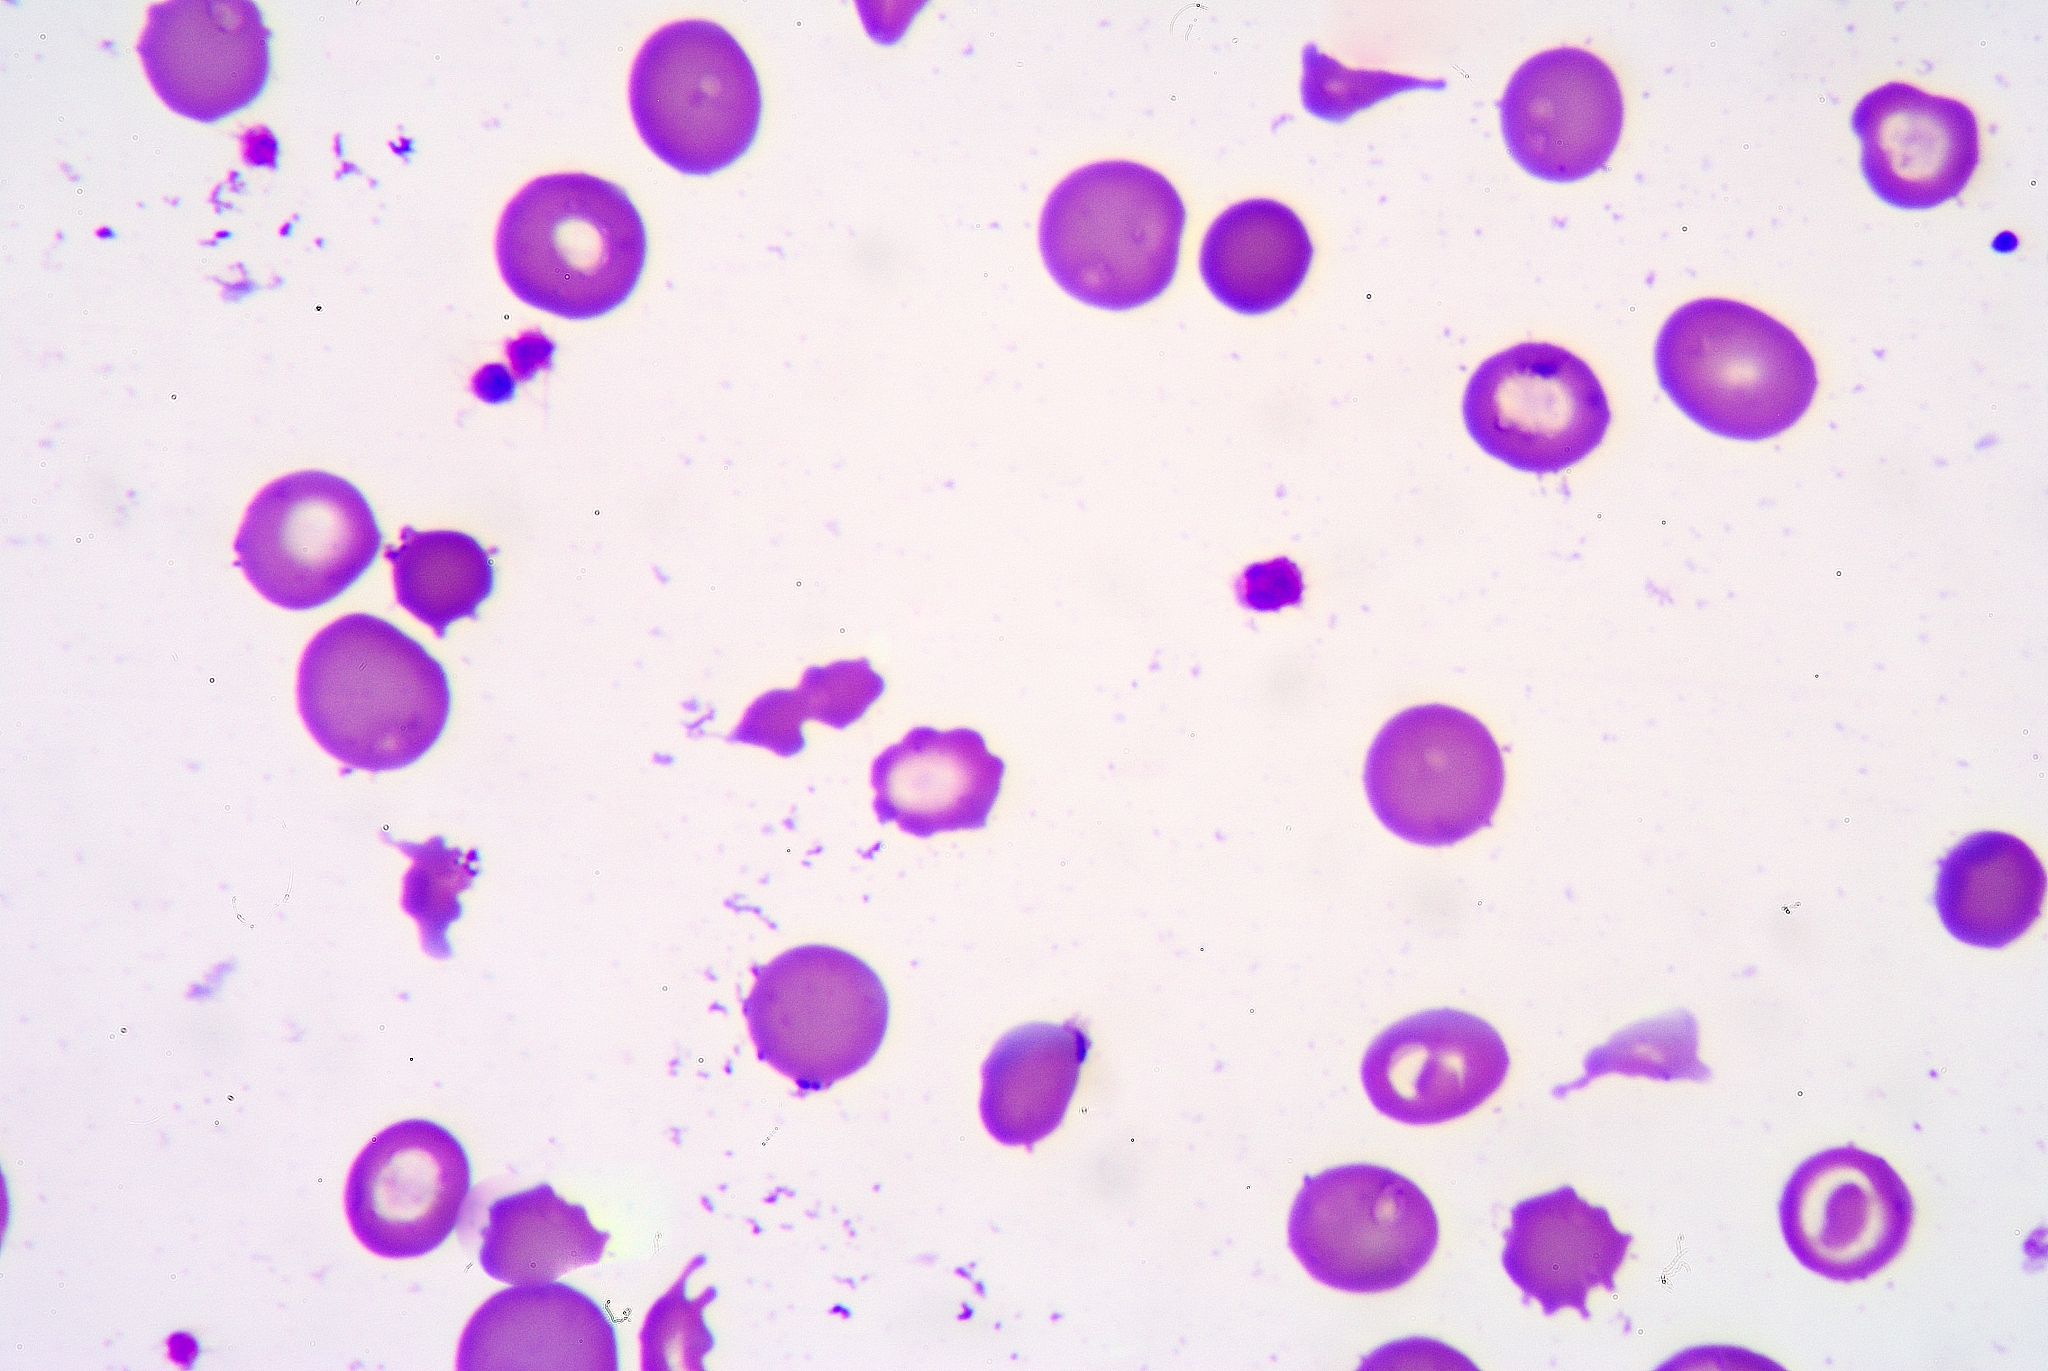
白细胞计数实验和血红蛋白含量测定实验讨论

白细胞计数实验和血红蛋白含量测定实验讨论
白细胞计数实验和血红蛋白含量测定实验是血液学中常用的实验方法。白细胞计数实验是测定血液中白细胞数量的方法,而血红蛋白含量测定实验是测定血液中血红蛋白含量的方法。
在白细胞计数实验中,通常使用显微镜和计数室来观察和计数白细胞数量。首先,需要将一定量的血液样本放置在计数室中,然后使用显微镜观察并计数白细胞数量。通常,白细胞计数的单位为每微升血液中的白细胞数量。
白细胞计数实验对于诊断和监测很多疾病都非常重要。例如,白细胞计数可以用于检测感染、肿瘤和其他疾病的存在和严重程度。
血红蛋白含量测定实验是测定血液中血红蛋白含量的方法。血红蛋白是血液中负责运输氧气的蛋白质,它的含量可以反映血液的氧合能力。血红蛋白含量测定通常使用血红蛋白分光光度计进行测定。分光光度计可以通过测量样品吸光度来确定血红蛋白含量。
血红蛋白含量测定实验对于诊断和监测贫血、缺氧等疾病非常重要。血红蛋白含量的变化可以反映血液中氧气运输的能力,因此可以用于评估和监测贫血和缺氧的严重程度。
原文地址: https://www.cveoy.top/t/topic/bvek 著作权归作者所有。请勿转载和采集!